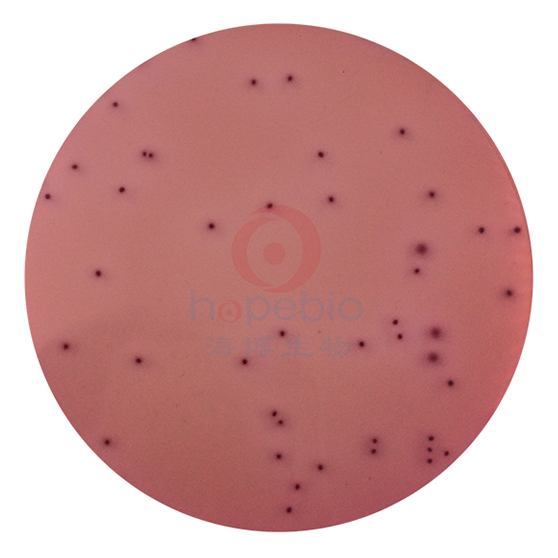
结晶紫中性红胆盐琼脂平板（9cm）

万千商家帮你免费找货
0 人在求购买到急需产品
- 详细信息
- 文献和实验
- 技术资料
- 保存条件:
请置于阴凉干燥处保存
- 保质期:
3个月
- 英文名:
Violet Red Bile Agar Plate
- 库存:
100
- 供应商:
青岛海博生物
- 规格:
10个/包
用于大肠菌群的固体平板检测
结晶紫中性红胆盐琼脂平板(9cm)微生物灵敏度试验:
接种以下质控菌株,放置36±1℃需氧培养18-24小时。
结晶紫中性红胆盐琼脂(VRBA)上细菌菌落特征:
|
|
|
| 结晶紫中性红胆盐琼脂(VRBA) 阴沟肠杆菌ATCC23355 |
结晶紫中性红胆盐琼脂(VRBA) 大肠埃希氏菌ATCC25922 |
风险提示:丁香通仅作为第三方平台,为商家信息发布提供平台空间。用户咨询产品时请注意保护个人信息及财产安全,合理判断,谨慎选购商品,商家和用户对交易行为负责。对于医疗器械类产品,请先查证核实企业经营资质和医疗器械产品注册证情况。
文献和实验成分 蛋白胨 17g 脙胨 3g 猪胆盐(或牛、羊胆盐) 5g 氯化钠 5g 琼脂 17g 蒸馏水 1000mL 乳糖 10g 0.01%结晶紫水溶液 10mL 0.5%中性红水溶液 5mL 制法 1 将蛋白胨、胨、胆盐和氯
水 1000mLpH7.0制法:除指示剂和甲液外,将其他成分加热溶解,不需消毒,校正pH后加入指示剂和甲液,倾注平板应呈草绿色。 注:①供沙门氏菌分离用。②Andrade指示剂和甲液的配制均见HE琼脂。 48 麦康凯琼脂成分:蛋白胨 17g眎胨 3g猪胆盐(或牛,羊胆盐) 5g氯化钠 5g琼脂 17g蒸馏水 1000mL乳糖 10g0.01%结晶紫水溶液 10mL0.5%中性红水溶液 5mL制法:1 将蛋白胨,眎,胆盐和氯化钠溶解于400mL蒸馏水中,校正pH7.2。将琼脂加入600mL加热溶解。将两液
0.1将基础培养基高压灭菌。 Irgasan以95%的乙醇作溶剂,溶解二苯醚,配成0。4%的溶液,待基础液冷至80℃时,加入1mL混匀。 冷至50℃时,加入:中性红(3mg/mL) 10.0mL结晶紫(0.1mg/mL) 10.0mL头孢菌素(1.5mg/mL) 10.0mL新生霉素(0.25mg/mL) 10.0mL最后不断搅拌着加入10.0mL的10%氯化锶,倒平皿。 70 嗜盐性试验培养基 成分:蛋白胨 2g氯化钠 按不同量加蒸馏水 100mLpH7.7制法:配制2%蛋白胨水,校正pH,共配制5瓶
技术资料暂无技术资料 索取技术资料